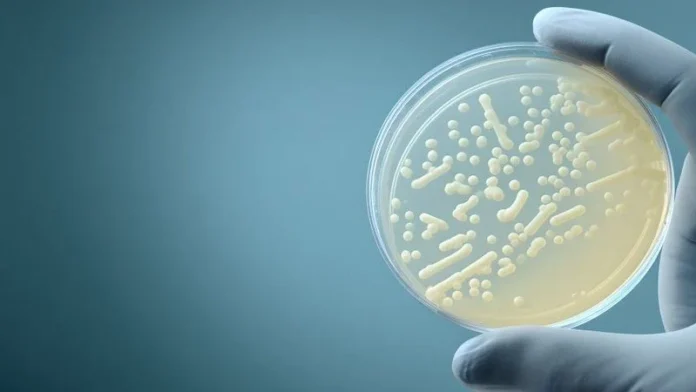

Cenário de Risco em Campinas
A Unidade de Terapia Intensiva (UTI) para adultos do Hospital Municipal Dr. Mário Gatti, em Campinas, foi temporariamente fechada na última terça-feira (10) após a confirmação de infecção por Klebsiella pneumoniae carbapenemase (KPC), uma bactéria multirresistente a antibióticos, em sete pacientes. A prefeitura de Campinas declarou que a decisão foi uma medida provisória, adotada com o objetivo de garantir um controle epidemiológico mais eficaz e a segurança no atendimento.
Isolamento e Transferência de Pacientes
Os pacientes diagnosticados com a KPC permanecem isolados em uma ala específica da UTI, sob os cuidados de uma equipe médica dedicada. Para assegurar a continuidade do tratamento de outros pacientes que necessitam de cuidados intensivos, eles serão transferidos para leitos de complexidade similar em outros hospitais da rede municipal. A central de regulação e o Serviço de Atendimento Móvel de Urgência (Samu) já foram instruídos a não encaminhar novos pacientes para a UTI do Mário Gatti, direcionando-os para unidades como o Hospital Ouro Verde ou outras disponíveis.
Plano de Contingência e Medidas Preventivas
A administração municipal ressaltou que a ocorrência de infecções em hospitais de alta complexidade é uma situação monitorada rotineiramente. Para combater a disseminação da superbactéria, estão sendo intensificadas medidas de higiene, como a limpeza rigorosa de leitos e a higienização das mãos, além de treinamentos específicos para as equipes de limpeza. Um plano de contingência foi apresentado ao Departamento de Vigilância em Saúde (Devisa) para análise, e as ações de controle serão mantidas até que a situação assistencial seja completamente estabilizada.
Entendendo a “Superbactéria” KPC
A Klebsiella pneumoniae é uma bactéria comum encontrada no ambiente e que pode colonizar o trato gastrointestinal e a nasofaringe humana. Ela é uma das principais causas de infecções hospitalares, especialmente em pacientes imunocomprometidos ou internados. Nas últimas décadas, cepas específicas desenvolveram resistência a múltiplos antibióticos, ganhando o nome de “superbactérias”. A resistência da KPC se dá principalmente pela produção de enzimas como carbapenemases, que neutralizam a ação de antibióticos de amplo espectro, incluindo os carbapenêmicos, considerados o último recurso no tratamento de infecções bacterianas graves.
Fonte: viva.com.br